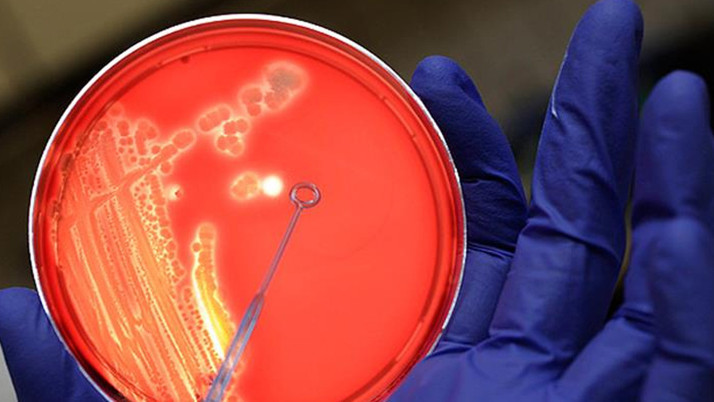
Ülkede bir hastalık tekrar hortladı! Yıllar sonra ilk ölüm

Tayland'da şarbon hastalığına yakalanan bir kişinin hayatını kaybettiği, bunun ülkede 1994’ten bu yana görülen ilk ölüm vakası olduğu bildirildi. Ülkede hastalığa yakalanan başka kişilerin de olduğu öğrenildi.
Abone olThe Nation gazetesinin haberine göre, hükümet, 1994 yılından bu yana şarbon hastalığından kaynaklanan ilk ölümün yaşandığını açıkladı.
Kuzeydoğudaki Mukdahan eyaletinde hafta içi şarbon hastalığına yakalandığı saptanan bir kişi yaşamını yitirdi. Aynı eyalette iki ayrı vakanın daha doğrulandığı, bazı şüpheli vakaların da araştırıldığı kaydedildi.
Bangkok Post'un haberine göre, ülkede son dönemde, potansiyel şarbon hastalığına maruz kalanların sayısı artıyor.
Yetkililer, ülke genelinde çiğ et tüketimine bağlı olarak şarbon hastalığına yakalanmış olabileceği düşünülen kişi sayısının 600’ü aştığını bildirdi. Bu kişilerin 30'dan fazlasının çiftlik hayvanları kestiği, geri kalanının ise çiğ ya da az pişmiş sığır eti tükettiği saptandı.
Kesim noktasının 5 kilometre çevresi karantinaya alınırken, etle temas edenler izlenerek tedaviye dahil edildi.
Şarbon hastalığı insana nasıl bulaşıyor?
Şarbon, insanlara hastalıklı hayvanlarla doğrudan temasın yanı sıra, yeterince pişirilmemiş veya hijyenik olmayan hayvansal ürünlerin tüketilmesi yoluyla da bulaşabiliyor.